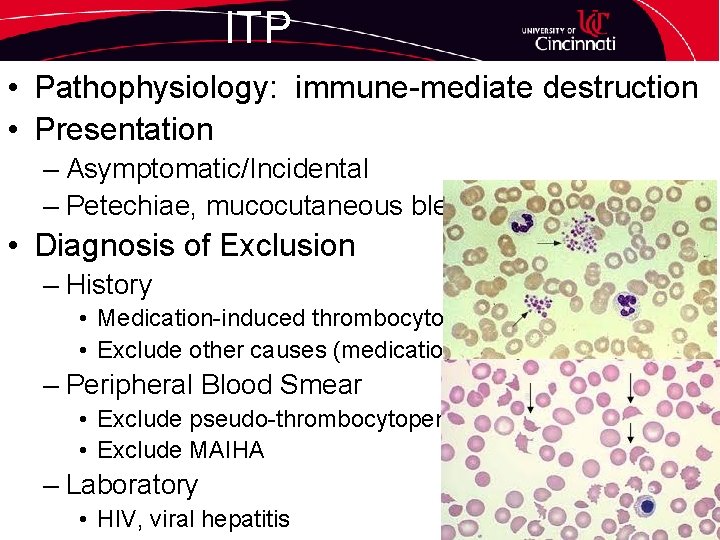
ITP • Pathophysiology: immune-mediate destruction • Presentation – Asymptomatic/Incidental – Petechiae, mucocutaneous bleed •

Platelet Bleeding and Thrombotic Disorders Saulius Girnius Hemostasis

Platelet, Bleeding, and Thrombotic Disorders Saulius Girnius

Hemostasis • Coagulation System has 2 functions – maintain hemostasis – Prevent/limit thrombosis • Clot Formation – Vascular injury vasospasm and platelet plug formation – Platelet activation, adhesion, aggregation – Fibrin clot formation • Limitation of Thrombosis – Control excessive clot formatoin – Fibrinoysis break down and remodel clot

Coagulation Cascade

Coag Interpretation PT/INR PTT Thrombin Time

Work Up for Prolonged Coags • History – Exclude presence of – Platelet Bleed – primary hemostasis • Mucocutaneous bleeding, petechiae, purpura – Coag Bleed – secondary hemostasis • Deep tissue: intramuscular hematoma/hemarthroses • Thrombin time: excludes heparin presence • Mixing Study – Correction: factor deficiency – No correction: presence of inhibitor • Measure individual factor

Platelet Disorders • Immune-mediated thrombocytopenia • Heparin-Induced Thrombocytopenia
ITP • Pathophysiology: immune-mediate destruction • Presentation – Asymptomatic/Incidental – Petechiae, mucocutaneous bleed • Diagnosis of Exclusion – History • Medication-induced thrombocytopenia • Exclude other causes (medications) – Peripheral Blood Smear • Exclude pseudo-thrombocytopenia (plt clumping) • Exclude MAIHA – Laboratory • HIV, viral hepatitis

Treatment • Indication – Plt Ct <30 – Plt Ct >30 and <50 if mucosal bleeding • Tx Options – IVIG: 1 gm/kg for 2 days if severe bleed, 100% RR – Corticosteroids: 70% RR, 40% long term remission – Splenectomy: in steroid-refractory, chronic ITP, 60% long term remission – Rituximab: CD 20 Ab: 33% sustained response – Thrombopoeitin Receptor Agonist • AE: bone marrow fibrosis, rebound thrombocytopenia • Eltrombopag: Oral, hepatotoxiciity • Romipolistim: IV qweek

Heparin-Induced Thrombocytopenia • Immune-mediated thrombocytopenia with Ab targeting heparin: PF 4 complex – Activates platelets and thrombin generation – Intensely hypercoagulable (arterial and venous) Thrombosis can occur prior to platelet nadir Blood. 2012; 120(20): 4160 -4167

HIT Work up • Antigen Assay HIT Ab Screening Test • Functional Assay Serotonin Release Assay Confirmatory • Treatment – Discontinue all heparin/LMWH containing products – Start anticoagulation • • Argatroban (hepatic elimination, OK to use in CRI) Fondaparinux Bivalirudin (Ok to use in liver disease) Lepirudin: No longer available in US – Warfarin: Only when Plt>150 Blood. 2012; 120(20): 4160 -4167

Question A 35 -year-old woman presents to the emergency department with a history of gum bleeding, epistaxis, and bruising for the last 5 days. She is otherwise healthy. On physical examination, her temperature is 98°F (36. 7°C), blood pressure is 110/70 mm Hg, and pulse rate is 80 beats/min. She has petechiae on her extremities and wet petechiae on her oral mucosal surfaces. Laboratory test results (sample drawn at admission): Hct= 30, Hgb= 10 g/d. L, Leukocyte count = 13, platelet = 7 She is immediately treated with intravenous immunoglobulin (IVIG), 1 g/kg for 2 days, and prednisone, 1 mg/kg, because of the concern for spontaneous bleeding. Two days after treatment begins, she reports dark urine. Laboratory test results: Hct= 21%, Hgb = 7. 0 g, ALC = 18, platelet 77 Her peripheral blood smear is notable for nucleated red blood cells and spherocytes. Which of the following is the most likely cause of her clinical condition? A. Paroxysmal nocturnal hemoglobinuria B. Disseminated intravascular coagulation C. IVIG-mediated hemolysis D. Thrombotic thrombocytopenic purpura

Answer (C) • The dark urine, acute drop in hemoglobin, and nucleated red blood cells suggest hemolysis is the cause of her anemia (Answer C). This hemolysis is most likely caused by the intravenous immunoglobulin (IVIG). Hemolysis can be seen in patients receiving IVIG for any number of underlying disorders. The mechanism is thought to be via the anti-A and anti-B antibodies contained in IVIG, leading to hemolysis in patients with blood type A or B. In addition to a positive result on direct antiglobulin testing, decreased haptoglobin and reticulocytosis are seen. The results of a Coombs test may be confusing because of nonspecific antibody coating on the red cells that can occur in the setting of IVIG therapy. The presentation can range from subclinical anemia, which often goes unnoticed, to marked hemolysis. Historically, hemolytic anemia caused by IVIG has been associated with high-dose treatment (as opposed to prophylactic dosing). This condition is self-limited and clinical intervention is generally not warranted. If transfusion is considered, group O red blood cells should be administered. Antiblood group antibodies should be assessed in the IVIG, with documentation of this episode as an adverse event. • Patients with suspected paroxysmal nocturnal hemoglobinuria (Answer A) do not typically present with severe thrombocytopenia. Disseminated intravascular coagulation (Answer B) and thrombotic thrombocytopenic purpura (Answer D) are unlikely causes given the platelet response to IVIG and the lack of schistocytes on peripheral smear.

Bleeding Diatheses • Von Willebrand’s Disease • Hemophilia A/B

Von Willebrand’s Disease • Most common inherited bleeding disorder • VW Mechanism of Action

Von Willebrand’s Disease • Clinical Presentation – Nose bleeds until puberty, menorrhagia, bleeding with surgery/dental extractions • Work Up – VW Antigen, VW Activity (Ristocetin Co. Factor) – Factor VIII – ABO Blood Group (O is low) • Type – Type 1: mild deficiency – reduction in Ag and Activity – Type 2: qualitative defect – reduction in activity – Type 3: absence of VWF/Factor 8

Von Willebrand’s Disease • Treatment – Desmopressin (DDAVP) • Type of VW: Type 1, IIA, IIM • Must prove efficacy with DDAVP stim test • Indication: Dental extractions, minor procedures, menorrhagia • AE: Tachyphylaxis, flushing, headache – VWF concentrate • • • Type of VW: Any Pts not responding to DDAVP Surgery with high bleeding risk (most surgeries) Trauma/emergent surgery Prophylaxis in Type 3

Hemophilia • X-linked, most commonly affect men • A is deficiency of FVIII, B is deficiency of FIX • Classification – Mild (>5 to 40%) – Moderate (1 -5%) – Severe (<1%) • Clinical Presentation – Mild: bleeding with surgery/trauma – Moderate: bleeding with surgery/trauma; occasional spontaneous bleeding – Severe: spontaneous hemarthroses, hematoma, ICH, epistaxis, ecchymoses

Management • Factor Replacement – On Demand • Indication: spontaneous hemorrhages, surgical prophylaxis • Administer until bleeding resolves – Prophylaxis • Use in severe hemophilia only • Administer 1 -3 x weekly to prevent spontaneous hemorrhage – Recombinant vs. plasma-derived • DDAVP for minor bleeds in Hemophilia A • Need trial to demonstrate response in FVIII

Question A 29 -year-old immigrant from Iran presents for evaluation of a possible bleeding disorder. He reports a history of recurrent bleeding events that started in early childhood. He describes 2 previous hemarthroses of the right knee, easy bruising, and hemorrhage requiring packed red blood cell transfusion after wisdom tooth extraction 10 years ago. On inquiring about the patient’s family history, you learn that one of his first cousins experienced an intracranial hemorrhage. Current laboratory test results: Hgb 15. , 2 Plt 180, PTT 23 s, PT 11 s, VW Activity 88%, VW Antigen 93%, VW mutimers normal, FVIII 89%, Clot solubility normal. Which of the following is the most appropriate management plan? A. B. C. D. E. Factor XIII concentrates Aminocaproic acid Platelet transfusion Recombinant factor VIIa Observation

Answer – (A) Work up of bleeding diathesis • Disorder of secondary hemostasis (coagulation pathway) include intracranial hemorrhage, perioperative bleeding, and joint and soft-tissue bleeds • Normal PTT essentially excludes Hemophilia A and B • Von Willebrand’s disease excluded by VW Activity, Antigen, and FVIII Level • Clot Solubility assay c/w F XIII deficiency Factor XIII deficiency • a rare, severe, autosomal recessive bleeding disorder most commonly identified in central Asia and in those of consanguineous birth. • Associated with impairment of wound healing • Both plasma concentrated factor XIII (Answer A) and recombinant factor XIII products are available and indicated for prophylaxis against bleeding

Venous Thrombosis • Inherited Risk Factors – Factor V Leiden – Activated Factor V resistant to inactivation by APC – Prevalence: 5 -7% of healthy, white population – Risk of VTE » Heterozygous: 2 -4 x » Heterozygous + estrogen oral contraceptive: 30 x » Homozygous: 80 x – Prothrombin G 20210 A – Prevalence: 3% of healthy, white population – Risk of VTE: 2 x – Other • Protein C, Protein S, Antithrombin III deficiencies

Venous Thrombosis • Antiphospholipid Antibody Syndrome – Sapporo Classification Criteria • Clinical Criteria: » >1 thrombosis (arterial, venous, small vessel) on imaging or histologic. SVT excluded » Pregnancy: (A) >1 fetal loss >10 weeks, (B) >1 premature bnirths prior to 34 weeks 2/2 pre-eclampsia, placental insufficiency, or (C) >3 spontaenous pregnancy losses <10 weeks. • Laboratory Criteria » Lupus anticoagulant activity » Ig. G or Ig. M anticardiolipin or beta 2 -glycoprotein >40 (99%) » Twice, at least 12 weeks apar

Thrombophilia Testing • Provoked VTE – No testing recommended (Choosing Wisely) • Unprovoked VTE – Factor V Leiden, Prothrombin gene mutation, Protein C and S activity, Anti-thrombin III, lupus anticoagulant, • Acute thrombosis can result in falsely low protein C, S and Antithrombin levels • False positive lupus anticoagulant: DOAC, Coumadin, heparin, LMWH, fondaparinux • Heparin: Decreases antithrombin levels • Warfarin: Decreases protein C and S levels

Treatment • Provoked VTE: 3 months • Unprovoked VTE – DVT: 3 -6 months – PE: 3 -6 months • Indications for Indefinite Anti-coagulation – Recurrent, unprovoked VTE – Life-Threatening VTE – Hypercoagulable state and personal h/o VTE

Types of Oral Anticoagulation • Vitamin K Antagonist – Titrate Coumadin dose to INR – Need to eat consistent Vitamin K amounts • Direct Oral Anticoagulants – Direct Thrombin Inhibitor • Dabigatran – Direct Xa Inhibitor • Rivaroxaban, apixaban, edoxaban – Compared to Coumadin, fewer CNS and upper GI bleed – Caution in CRI and elderly – Drug-drug interaction: Azoles, CCB, anti-epileptics

Question A 35 -year-old woman presents to clinic for discussion of anticoagulation after a venous thrombotic event. Three months before today’s visit, a venous thrombosis in the tibial vein of the patient’s right calf (below the knee) was diagnosed by compression venous ultrasonography. The patient had traveled by car approximately 4 hours during the previous week. She had no antecedent surgery, trauma, hospitalization, or other immobility. She was taking oral contraceptive pills at the time of her deep venous thrombosis, but has since ceased their use. The patient’s family history includes pulmonary embolism in her sister. Thrombophilia evaluation at that time identified the patient to be heterozygous for the factor V Leiden mutation. No other inherited thrombophilia was identified. After the patient’s thrombotic event, she was prescribed enoxaparin and her regimen was transitioned to warfarin with a target INR of 2 to 3. She has been adherent to regular monitoring, and INR values have been within the target range. She has no history of bleeding complications. She has had no complications with warfarin therapy, although she finds regular INR monitoring inconvenient. (https: //www. ashacademy. org/ASHSAP/question/index/376) Which of the following is the most appropriate treatment strategy? A. B. C. D. E. Continue current warfarin dosage without change in target INR Continue warfarin with a reduced INR target of 1. 5 to 2. 0 Discontinue warfarin Switch from warfarin to rivaroxaban Interrupt warfarin therapy for 1 month and then measure D-dimer

Answer (C) • There are 2 rationales for a shorter course of AC – (1) the clot was distal (tibial vein of the calf). Risk of recurrent is ½ that of proximal DVT – (2) the clot was provoked (oral contraceptive pills). • Heterozygosity for the factor V Leiden allele only mildly increase risk of recurrent VTE • Current guidelines recommend 3 months of anticoagulation therapy after a distal lower-extremity venous thrombosis. • A longer duration of anticoagulation as secondary prevention should be weighed against the risk of bleeding complications in patients with proximal deep venous thrombosis (Answers A and D). • Low-intensity warfarin (Answer B) provides no reduction in bleeding complications. • D-dimer measurement (Answer E) may be helpful in stratifying recurrence risk in patients with unprovoked, proximal deep venous thrombosis or pulmonary embolism, but it is not suggested in the setting of distal venous thrombosis.

• Questions? ?
- Slides: 28